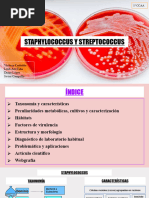

0% encontró este documento útil (0 votos)
46 vistas8 páginasInfecciones y características de Staphylococcus y Streptococcus
Este documento trata sobre Staphylococcus y Streptococcus, incluyendo sus características, factores de infección, patogenia, diagnóstico y tratamiento. Describe las especies más comunes de Staphylococcus, sus toxinas y enzimas, y los genes asociados con resistencia a antibióticos. También cubre prevención e identificación microbiológica.
Cargado por
mgondraramDerechos de autor
© © All Rights Reserved
Nos tomamos en serio los derechos de los contenidos. Si sospechas que se trata de tu contenido, reclámalo aquí.
Formatos disponibles
Descarga como PDF, TXT o lee en línea desde Scribd
0% encontró este documento útil (0 votos)
46 vistas8 páginasInfecciones y características de Staphylococcus y Streptococcus
Este documento trata sobre Staphylococcus y Streptococcus, incluyendo sus características, factores de infección, patogenia, diagnóstico y tratamiento. Describe las especies más comunes de Staphylococcus, sus toxinas y enzimas, y los genes asociados con resistencia a antibióticos. También cubre prevención e identificación microbiológica.
Cargado por
mgondraramDerechos de autor
© © All Rights Reserved
Nos tomamos en serio los derechos de los contenidos. Si sospechas que se trata de tu contenido, reclámalo aquí.
Formatos disponibles
Descarga como PDF, TXT o lee en línea desde Scribd